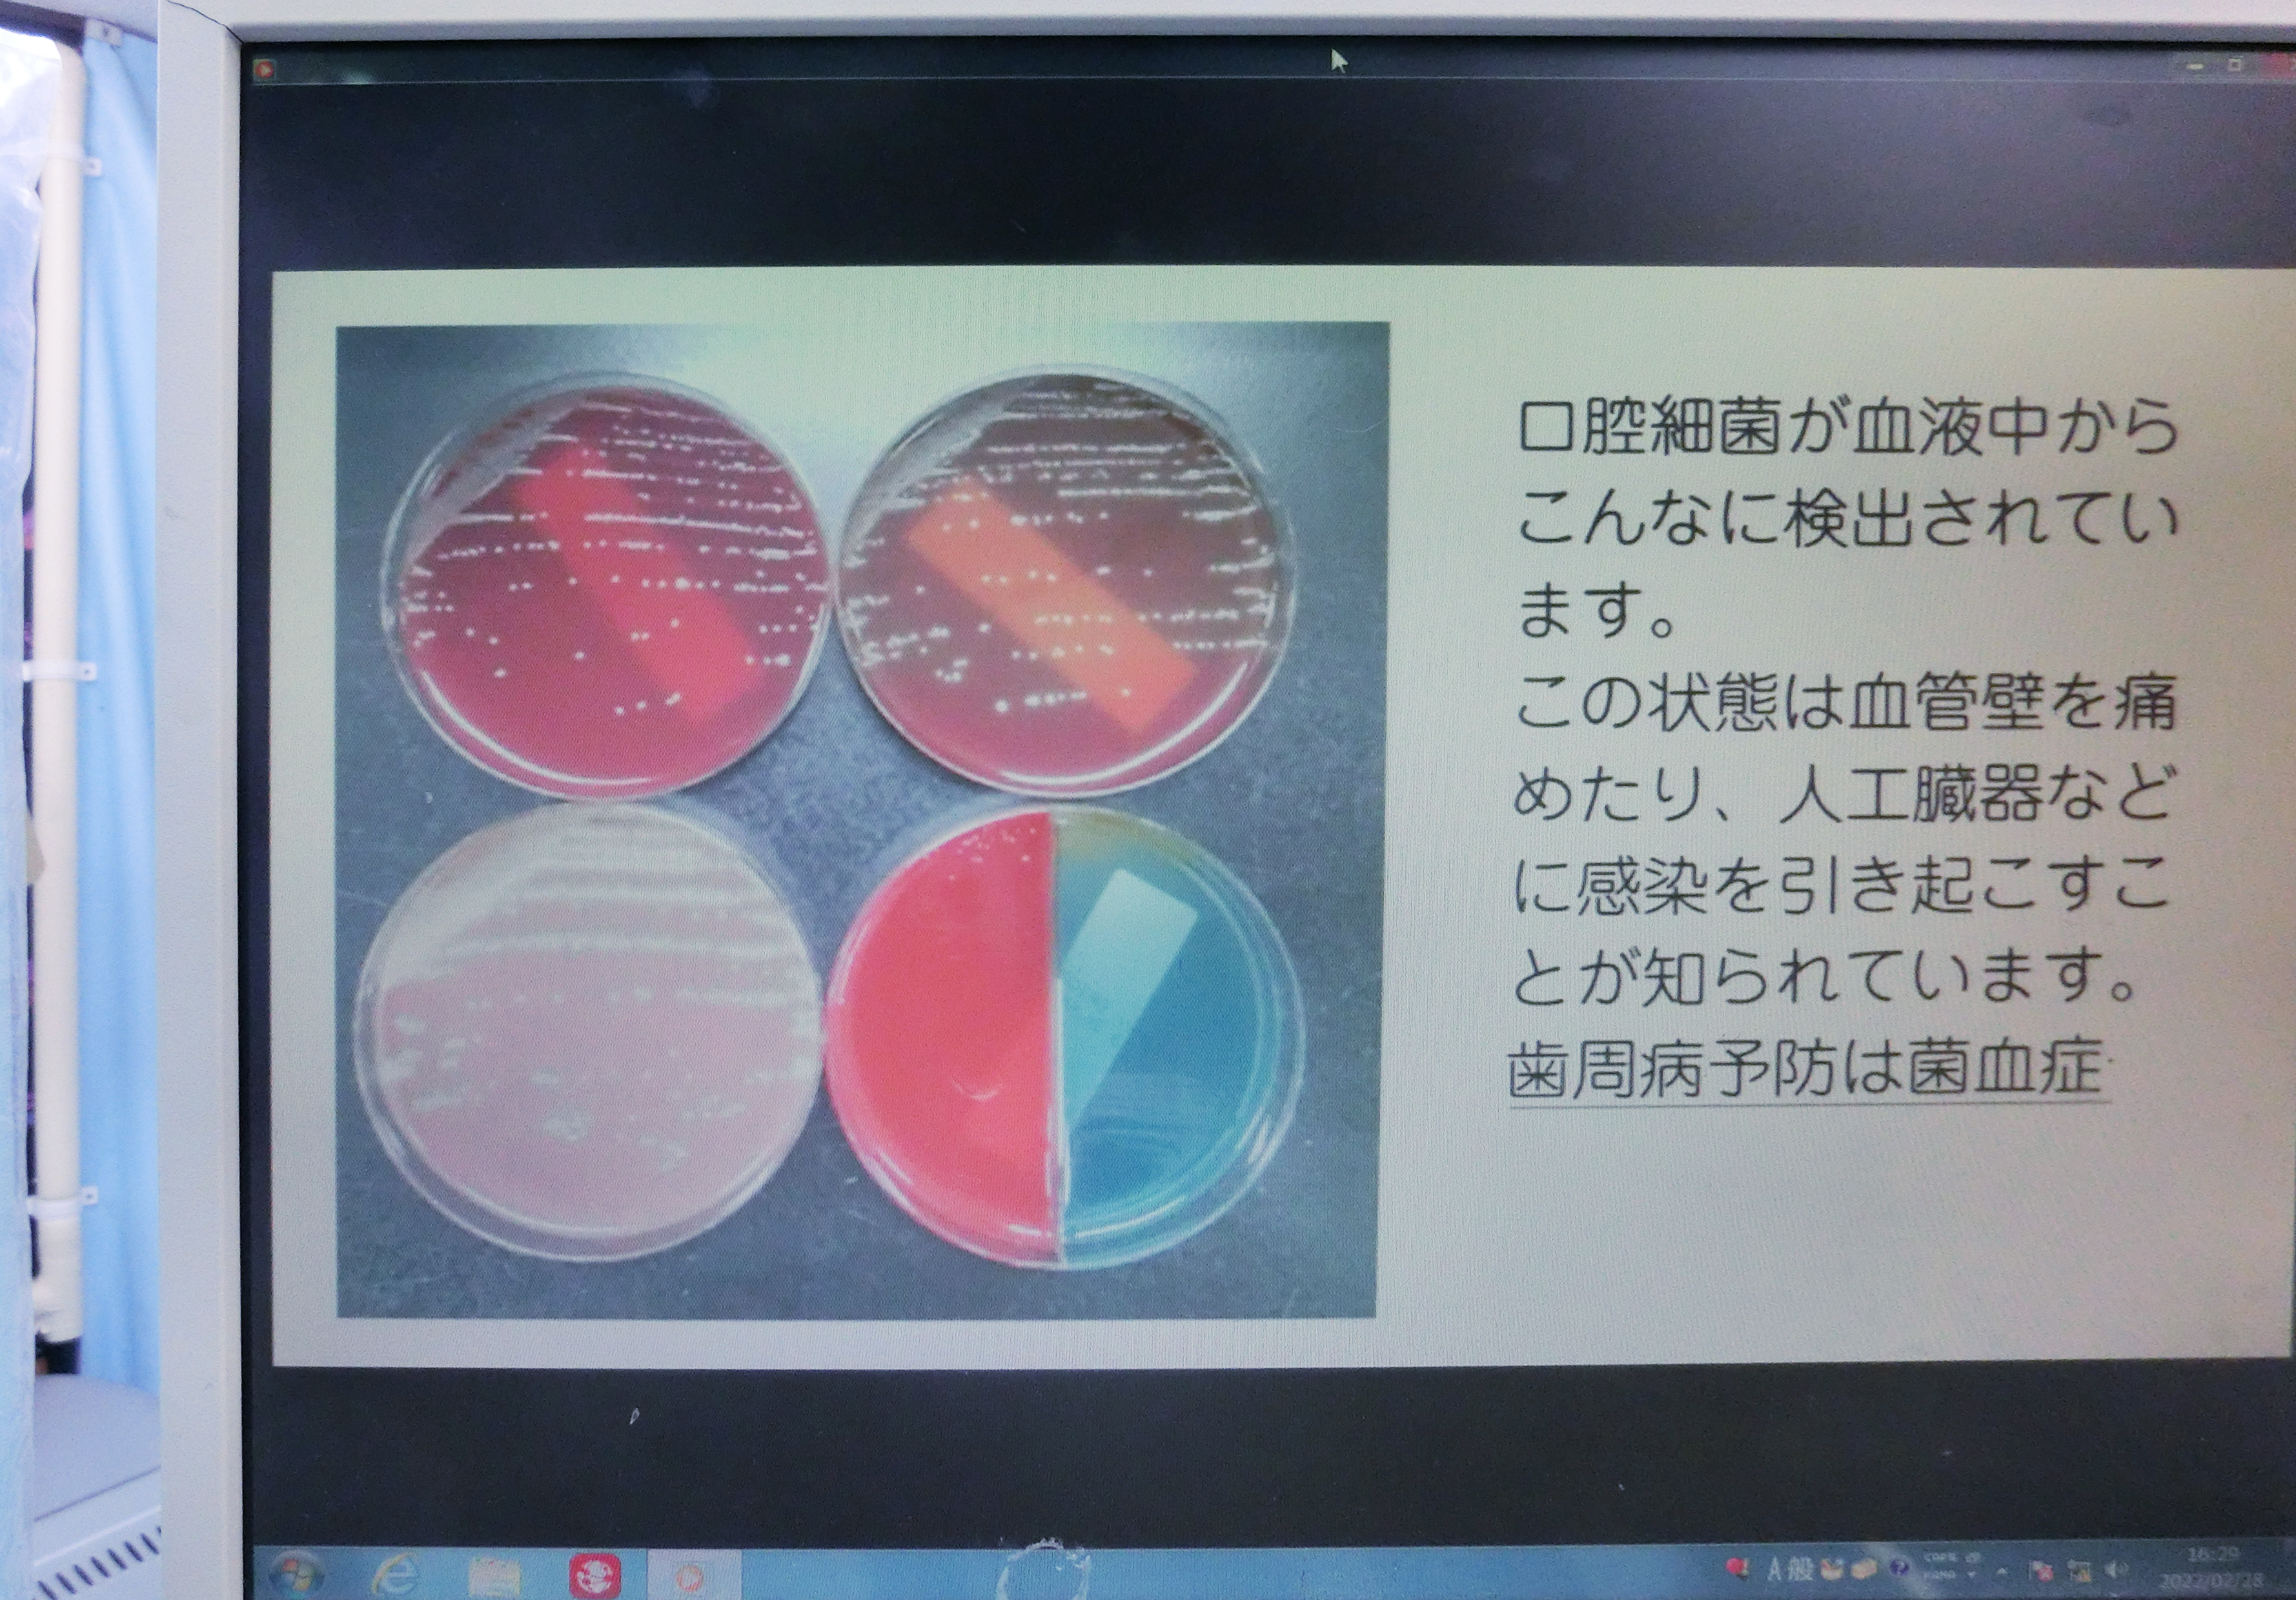
CIMG9305 - むらたまこと_re

歯周病を知るツール
こんにちは。院長の村田です。
歯周病は成人の80%以上が罹患している感染症です。
ところがこの疾患について正しい知識をお持ちの方は少ないと思われます。
しかし今では全身疾患と密接な関係があることがわかってきました。
歯周病と全身病との関連性を知ることはとても大切なことです。
我々の医院では歯周病と診断した患者さんにはこうした説明ツールを駆使して、
十分に納得されたうえで治療を開始することにしています。

【お知らせ】
来月より保険点数の改定による診療が始まります。
ちなみに当院は歯周疾患検診実施医療機関として認定されました。
勝田歯科医院
〒224-0034 神奈川県横浜市都筑区勝田町294-3 2F
TEL:045-591-2918
URL:http://www.dental-kachida.com/
Googleマップ:https://g.page/r/CcPzQX1KiHBFEAE

